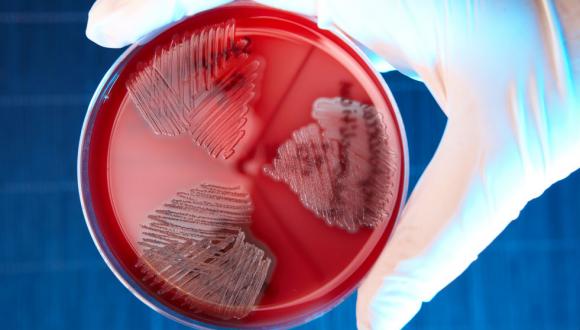

חוקרים ישראלים ממכון וויטהד, בוסטון ומאוניברסיטת תל-אביב פיתחו אלגוריתם המאפשר למצוא את שם המשפחה של אדם על סמך מידע גנטי בכרומוזום הY-. למחקר עשויות להיות השלכות משמעותיות בנושא של פרטיות המידע


מחקר
חוקרים ישראלים ממכון וויטהד, בוסטון ומאוניברסיטת תל-אביב פיתחו אלגוריתם המאפשר למצוא את שם המשפחה של אדם על סמך מידע גנטי בכרומוזום הY-. למחקר עשויות להיות השלכות משמעותיות בנושא של פרטיות המידע

עובר בגנים
"מאז שהתפתחה היכולת לרצף את הגנום האנושי, מבקשים אנשים רבים להתחקות אחר השושלת הגנטית שלהם", מסביר פרופ' ערן הלפרין, חוקר ומרצה בבית הספר למדעי המחשב ובמחלקה למיקרוביולוגיה וביוטכנולוגיה באוניברסיטת תל-אביב. "כדי לענות על הצורך, קמו בארה"ב חברות שנוטלות מהמעוניינים דגימות רוק, ומעלות את הגנום האישי שלהם למאגרי נתונים הפתוחים לציבור. אנחנו נעזרנו במאגרים אלה כדי לבחון השתייכות משפחתית על פי כרומוזום ה-Y, כרומוזום המין הגברי. כרומוזום ה-Y התאים במיוחד למחקר שלנו, מכיוון שהוא עובר מאב לבנו לאורך הדורות (עם שינויים קלים הנובעים ממוטציות), ולכן, ממש כמו שם המשפחה, הוא משותף למעשה לכל הגברים במשפחה המורחבת".
המחקר המקורי, פרי יוזמתו של ד"ר יניב ארליך ממכון ווייטהד למחקר ביו-רפואי שבבוסטון, ובהשתתפות פרופ' הלפרין והדוקטורנט דוד גולן מהמחלקה לסטטיסטיקה באוניברסיטת תל-אביב, התמקד בבניית אלגוריתם ממוחשב, שיידע לקבוע את שם משפחתו של אדם אך ורק על פי נתוני כרומוזום ה-Y שלו.
אחד משמונה
האלגוריתם המיוחד נבחן על מדגם של 900 גברים בארה"ב. נתוני כרומוזום ה- Yשל המשתתפים הוצגו למאגר אינטרנטי ובו גנומים מרוצפים של 135,000 בני אדם – שמהווים ייצוג נאמן להתפלגות שמות המשפחה בארה"ב, בעיקר כאלה שבאים ממוצא אירופי. "האלגוריתם זיהה במדויק את שם המשפחה של אחד מכל 8 נבדקים", אומר פרופ' הלפרין.
במקרה אחר הצליחו החוקרים להתחקות אחר שמו ואחר מיקומו של אדם מסוים על פי שילוב של כרומוזום הY- שלו , גילו והעובדה שהוא מתגורר בקליפורניה. כך, לדוגמה, הם הציגו לאלגוריתם את נתוני כרומוזום ה-Y של הגנטיקאי הידוע קרייג ונטר (Craig Venter), שפרסם את כל הגנום שלו ברשת. האלגוריתם זיהה את שם המשפחה, ולאחר הצלבת השם עם נתונים נוספים - גילו של ונטר, והעובדה שהוא מתגורר בקליפורניה - צומצם החיפוש לשני אנשים בלבד. כמו כן הצליחו החוקרים לזהות כמעט בוודאות משפחה מורמונית גדולה מיוטה, על פי כרומוזומי ה-Y של בניה.
זהות חשופה
"לטכניקת הזיהוי שפיתחנו יכולים להיות לא מעט שימושים מועילים, כמו איתור קרובים, זיהוי גופות באסונות טבע ועוד", אומר פרופ' הלפרין. "עם זאת, המחקר שלנו חשף בעיה מהותית שדורשת התייחסות: אם אדם מפרסם את הגנום שלו באינטרנט, גם כשהדבר נעשה בעילום שם, זהותו חשופה למדי, וצריך לזכור שאנחנו בדקנו כרומוזום אחד בלבד מתוך כלל המידע הגנטי, שכולל עוד 22 כרומוזומים. למרות זאת חשוב לציין כי אנו רואים בחיוב את שיתוף המידע הגנטי במסדי מידע ציבוריים, בהסכמה כמובן. שיתוף המידע חיוני לקידום המדע וישנם יתרונות רבים למשתמשים בשירותים אלו. אולם, חשוב שכל הגופים הקשורים לשיתוף המידע, כולל האנשים אשר נתוניהם נמצאים במסדי המידע, המדענים והגופים המפרסמים את המידע יהיו מודעים לאופי החשיפה ויפעילו את שיקוליהם בהתאם".
ד"ר יניב ארליך מציין כי: "מסקנה מתבקשת מהמחקר שלנו היא שמאגרים ביומטריים יכולים ליצור מצבים בלתי צפויים. לדוגמא, מי חשב ששמות משפחה יכולים להתגלות ממידע גנטי. לכן אנו מאמינים שמחוקקים צריכים לנקוט במשנה זהירות כאשר הם מתכננים מאגרים כאלו".

מחקר
מחקר שנערך בפקולטה לניהול מראה כי לחשיבה סטראוטיפית גזענית ולהגבלה ביצירתיות יש הרבה יותר מן המשותף ממה שנדמה לנו - שתיהן מושפעות מחשיבה קטגורית

ד"ר כרמית תדמור, מומחית להתנהגות ארגונית בחוג למנהל עסקים, ועמיתיה, גילו במחקר חדש כי חשיבה סטריאוטיפית וקיפאון יצירתי חולקים מכנה משותף: חשיבה קטגורית. "אף על פי ששני התחומים מובילים לתוצאות שונות, שניהם מתרחשים כאשר אנשים מתקבעים על תבניות מידע מוכרות והלכי רוח קונבנציונליים", מסבירים החוקרים.
במחקרם ביקשו החוקרים לבדוק האם יכול להיות קשר סיבתי בין גזענות מהותנית - הדעה כי אנשים מגזע מסוים הם בעלי מהות מולדת שכוללת תכונות ויכולות אשר אינן ניתנות לשינוי, לבין יצירתיות. הם העלו השערה כי ברגע שתופעל תצורת החשיבה המהותנית היא תוביל להגבלה בחשיבה על נקודות מבט אלטרנטיביות ותביא לצרות ראייה כללית.
חשיבה קטגורית פוגעת ביצירתית
באחד מארבעה ניסויים שנערכו במסגרת המחקר, חולקו המשתתפים לשלוש קבוצות: בקבוצה אחת, התבקשו הנבדקים לקרוא מאמר מדעי פיקטיבי התומך בדעות קדומות על סמך גזע, בקבוצה השנייה התבקשו לקרוא מחקר פיקטיבי התומך באמונות גזעיות שאינן מהותיות, כלומר ניתנות לשינוי, ובקבוצה השלישית קראו הנבדקים מחקר מדעי על המאפיינים המדעיים של מים.
בשלב השני נבחנו המשתתפים במבחן אסוציאציות הבודק יצירתיות. במבחן הוצגו בכל פעם שלוש מילים, ועל הנבדקים הוטל למצוא מילת מטרה המשותפת לשלושתן, לדוגמא, מילה משותפת למילים: "עגול", "טניס" ו-"נימוסין", יכולה להיות "שולחן". החוקרים מצאו כי משתתפי הקבוצה הראשונה, שנחשפו לתפיסת עולם גזענית מהותנית היו פחות יצירתיים והצליחו לפתור נכונה פחות תרגילי מילים מאשר המשתתפים בשתי הקבוצות האחרות.
כשהקופסא נסגרת
תוצאות של מחקר עוקב שערכו החוקרים הראה כי הקשר בין גזענות מהותנית ויצירתיות ירודה, יכול להיות מוסבר, לפחות בחלקו, בעלייה בקיבעון מחשבתי. לדברי ד"ר תדמור, "אנשים האוחזים בתפיסה הזו מסתכלים בקטגוריות חד משמעיות וסבורים שדברים לא יכולים להתערבב, לא יכולים לעבור מקבוצה אחת לאחרת. יצירתיות מהגדרתה דורשת לפרוץ מחסומים בין קטגוריות ולחשוב מחוץ לקופסה". בנוסף מדגיש הניסוי כי גם החשיפה לעמדות קבועות וגזעניות לבדה, גם אם אינן מקובעות מבעוד מועד, משפיעה על דרך החשיבה ומצמצמת את המחשבה היצירתית.
מגזענות לסובלנות
המחקר מציע כי דעות מהותניות ניתנות לשינוי יחסית בקלות. אף על פי שישנם עדיין היבטים רבים שטרם נחקרו, תדמור וקבוצתה משערים שניתן להשתמש בממצאים שהעלו על מנת לעצב תכנית התערבות אשר תוריד את רמת הדעות המהותניות ותוביל משתתפים לא רק לסבלנות חברתית גדולה יותר אלא גם לשחרור הפוטנציאל היצירתי שלהם כחלק מהתהליך.
מחקר
מחקרם פורץ הדרך של החוקרים מבית הספר לפסיכולוגיה באוניברסיטת תל-אביב עשוי להוביל לשיטות חדשות לאבחון המחלה ולפיתוח תרופות חדשות ל-OCD

חוקרים בבית הספר למדעי הפסיכולוגיה באוניברסיטת תל-אביב הראו לראשונה כי חשיפה לחיידק הגורם לדלקת גרון מהסוג השכיח בגיל הילדות עלולה להוביל לפגיעה בתפקוד המוח ולהפרעות נוירופסיכיאטריות.
זה יותר מעשרים שנה, רווחת בקהילה המדעית ההשערה לפיה הפרעה טורדנית כפייתית עשויה להיות קשורה במחלות ילדים מדבקות דוגמת דלקות גרון. פרופ' דפנה יואל וצוות החוקרים שלה בבית הספר למדעי הפסיכולוגיה באוניברסיטת תל-אביב, הציגו לראשונה הוכחה מדעית לאפשרות לגרימת הפרעה כזאת כתוצאה מחשיפה לחיידק סטרפטוקוקוס A הגורם בבני אדם לדלקת גרון. לדברי פרופ' יואל, פריצת הדרך המחקרית הזאת עשויה להוביל לפיתוח תרופות חדשות ל-OCD.
מחשבות אינטנסיביות ופעילות כפייתית
על פי נתוני האקדמיה האמריקאית לפסיכיאטריה של הילד והמתבגר, סובלים עד 2% מהילדים והמתבגרים בארה"ב מ-OCD. ההפרעה הזאת מאופיינת במחשבות אינטנסיביות החוזרות על עצמן, או בפעילות כפייתית העלולה לגרום לחוסר נוחות, חרדה ומתח, ולהפריע לתפקוד היום-יומי.
המחקר התבצע על ידי הדוקטורנטית לפסיכולוגיה, ליאור ברימברג, בשיתוף פעולה עם פרופסור מדליין קנינגהם מאוניברסיטת אוקלהומה, מומחית באימונולוגיה ובמחלות אוטואימוניות הקשורות לזיהום בסטרפטוקוקוס A, והתוצאות התפרסמו לאחרונה בכתב העת Neuropsychopharmacology.
פרופ' יואל מסבירה כי "כמעט בלתי אפשרי להראות כיצד יכולה דלקת הגרון להוביל להפרעה טורדנית כפייתית בבני אדם כיוון שכמעט כולנו נחשפנו לחיידקים אלו בזמן זה או אחר". העבודה המשותפת עם פרופ' מדליין קנינגהם, הנחשבת לאחת המומחים המובילים בעולם בתחום מחלות לב הקשורות לחשיפה לסטרפטוקוקוס, הובילה לפיתוח מודל חדש בבעלי חיים, המציג את האופן שבו חשיפה לחיידק משפיעה על המוח ומובילה לשורת הפרעות מוטוריות והתנהגותיות.
הנוגדנים לחיידק מתמקמים במוח
במעבדתם באוניברסיטת תל-אביב, יצרו פרופ' יואל וליאור ברימברג מודל של המחלה, תוך שהן משתמשות בחולדות שנחשפו לחיידקי strep. השוואת החולדות האלה לקבוצת בקרה של חולדות שלא נחשפו לחיידק, אפשרה למדוד ולזהות שינויים ברורים בהתנהגות החיות שנחשפו לחיידק. יש להבהיר כי החולדות עצמן לא לוקות במחלה, אלא רק מייצרות נוגדנים נגד החיידק. נוגדנים אלה הם הגורמים להפרעות ההתנהגותיות.
המחקר העלה כי החולדות שנחשפו למחלה פיתחו נוגדנים שהתמקמו במוח, בתהליך שאישר את החשדות אותם העלו חוקרים שונים בעבר. החולדות שנחשפו לחיידק פיתחו קשיים באיזון ובקואורדינציה, כמו גם גילויים של התנהגות כפייתית דוגמת עיסוק מוגבר בניקיון.
ממצא חשוב במיוחד של החוקרות הוא העובדה לפיה הנוגדנים ל-strep נקשרים לקולטנים לדופאמין מסוג D1 ו-D2, הממוקמים במוח. הממצא הזה עולה בקנה אחד עם העובדה לפיה אחת התרופות המרכזיות ל- Sydenham's Chorea, הפרעה מוטורית הקשורה ל-strep – מתמקדת בדיוק בקולטנים לדופאמין מסוג D2. ואכן, גם במודל, טיפול בחולדות שנחשפו לחיידק בתרופה החוסמת רצפטורים מסוג D2 הביאה להקלה בהפרעה המוטורית.
פרופ' יואל מדגישה, כי המחקר מצביע על חשיבות מתן תשומת לב הולמת לכל דלקת גרון, על מנת להבטיח טיפול נכון ושימוש מושכל באנטיביוטיקה במקרה של זיהום בסטרפטוקוקוס A.

מחקר
מדוע אנו רוצים לדעת ש"אכלנו אותה"? לא תמיד חיפוש או הימנעות מאינפורמציה נעשים במטרה לשפר תהליכי קבלת החלטות, אלא לעיתים מהווים מקור בלתי תלוי לוויסות רגשות הנאה וכאב הכרוכים בידיעה עצמה

המידע שמאחורי ההחלטה
מקובל לומר כי אנשים עושים שימוש בידע על מנת לשפר תהליכי קבלת החלטות. אכן, החלטות המבוססות על ידע הן בדרך כלל החלטות טובות ומושכלות יותר. עם זאת, בסדרת מחקרים, הראה ד"ר יניב שני מהפקולטה לניהול ע"ש רקאנטי, כי בני אדם מחפשים במקרים רבים מידע לא רלוונטי, ככלי לוויסות תחושותיהם לגבי החלטות שכבר קיבלו. יתרה מזאת, מדובר בעיקר בחיפוש מידע בעל אופי שלילי, אשר מוכיח בסופו של יום שההחלטות שקיבלו לא היו הטובות ביותר.
רוכשים במבצע מחפשים מידע על מבצעים טובים יותר בהם יכלו לרכוש את המוצר, משקיעים במניות בוחנים את התנהגות המניה גם אחרי שמכרו אותה כדי לגלות אם עלתה, ואפילו בני זוג ממשיכים להתעדכן בנוגע לבני זוג קודמים, גם אחרי שנפרדו דרכיהם, למרות שהמידע כבר אינו רלוונטי עבורם והפוטנציאל להיפגע ממנו הוא גבוה. יתרה מכך, המחקר הראה כי אנשים נוטים לחפש את המידע דווקא כאשר הם חושדים שימצאו אינפורמציה לא נעימה. למעשה, חיפוש האינפורמציה לרוב נפסק בעיקר כאשר נחשפת האינפורמציה הלא נעימה (לדוגמא, כאשר אני מגלה שיכולתי לקנות מוצר במחיר מופחת) ולא כאשר נחשפת אינפורמציה נעימה יחסית (קניתי את המוצר במחיר טוב).
חוסר וודאות
לחוסר הוודאות תפקיד משמעותי בהגברת התחושה הלא נעימה הקשורה במחשבה ש"מצבנו יכול היה להיות טוב יותר". בסדרת המחקרים הוכח כי עצם המחשבה שהחמיצו הזדמנות לרווח נוסף לו השקיעו במניה אחרת, שצלם החתונות רימה אותם או אפילו שהאקס\ית מאושר\ת במערכת היחסים החדשה שלו\ה, הרבה פחות נעימה לאנשים, לעומת הרווח הרגשי שקיבלו מאישור חשדותיהם.
אז למה אנו בכל זאת מתעקשים לגלות דברים שאנו יודעים שיגרמו לנו לעוגמת נפש? הצורך להקטין את תחושת חוסר הוודאות חזק במיוחד כשאנשים מצפים ל"גרוע מכל", ומוביל לחיפוש אינפורמציה ודאית גם במחיר מציאתה, מהסיבה הפשוטה שעצם הידיעה "סוגרת" את הנושא ומאפשרת "להמשיך הלאה".
אחרי החגים
המחקר האחרון בסדרה עסק בהימנעות ממידע ובדק מתי אנשים מעדיפים להימנע מאינפורמציה, גם כשמדובר במידע חשוב ומשמעותי. מחקר זה מצא כי יש סיטואציות בהן אנשים מעדיפים להתעלם ממידע רלוונטי וחשוב שיכול להשפיע על התנהגותם והחלטותיהם, ושהם סקרנים מאד לגבי תוצאותיו. המשותף לאותן סיטואציות הן שבכולן מדובר על פעילות נעימה צפויה, הגורמת לנו לוותר על מידע ולדחות את קבלתו עד לאחר סיום הפעילות.
לדוגמא, סביר שאנשים יעדיפו לדחות קבלת תוצאות של בדיקת איידס לקראת חופשה מתוכננת בתאילנד ולקבל את המידע רק לאחר חזרתם. זאת, אף על פי שמדובר בבדיקה שהם יזמו. לידיעה האם המצב הבריאותי האישי תקין או לא תקין השלכות על התנהגותם במהלך החופשה. מבחינה אינטואיטיבית, הרצון "לא לקלקל את החופשה" עם מידע לא נעים נשמע מאד הגיוני. אך מדובר ביותר מכך - ידע פירושו וודאות, וודאות משפיעה על בחירותינו לכאן או לכאן. יציאה לחופשה במצב של חוסר וודאות לגבי המצב הבריאותי, מעניקה תחושה כי ניתן לעכב את שינוי ההתנהגות, ולהמשיך לפעול כפי שפעלנו עד כה, אולי אף בחוסר אחריות מסוים, עד שתתקבל הידיעה.
לפעמים עדיף לא לדעת
בהימנעות ממידע לקראת מאורע נעים יש הימנעות מחרטה, מדילמות, מרגשות מורכבים. מדובר במנגנון נוסף של וויסות הרגשות – הפעם באמצעות הימנעות ממידע. הבעיה מתחילה כשלאינפורמציה ולהיעדרה יש השלכות על הביצועים, ההתנהגויות והפעולות בהמשך, לאדם עצמו ולסובבים אותו. הדבר ניכר במיוחד בהקשר של ניהול מידע רפואי, אבל לא רק. ניהול מידע פיננסי וקבלת החלטות כלכליות גם הן מושפעות ממידע שהאדם בוחר להימנע ממנו. קבלת החלטות עסקיות מושפעת מניהול האינפורמציה, ולא פעם, במודע או שלא במודע, אנחנו נמנעים מחשיפה למידע שעלול "לקלקל" לנו את החוויה החיובית, בין אם מדובר בסגירת עסקה חשובה, רכישת מוצר, או הפקת אירוע.
אין ספק כי מודעות לנטייה זו והכרה בעובדה כי כשאין לנו מידע אנו נוטים לסכן ולהסתכן יותר, היא חשובה ונדרשת כפועל יוצא יישומי של ממצאי המחקר, בין אם מדובר בבריאות, בעסקים ובשאר תחומי החיים. חשוב אם כן לזכור, כי לא תמיד חיפוש או הימנעות מאינפורמציה נעשים במטרה לשפר תהליכי קבלת החלטות (לא משנה כמה נאמין בכך), אלא לעיתים מהווים מקור בלתי תלוי לוויסות רגשות הנאה וכאב הכרוכים בידיעה עצמה. לעיתים אנשים יימנעו מאינפורמציה כאשר ירגישו ש"אין זה הזמן הנכון" להתמודד עמה. במקרים אחרים, יחפשו את האינפורמציה, כאשר יחושו ש"הציפייה לגרוע מכל" גרועה הרבה יותר "מהגרוע מכל".

מחקר
פרופ’ עמנואל פלד וד"ר דיאנה גולודניצקי מבית הספר לכימיה מפתחים מצברים ננו-מטריים שניתן להתקינם, בין השאר, בתוך קפסולות לבליעה למטרות רפואיות, או בחיישנים זעירים - לשימושים ביטחוניים

חוקרים בכל העולם מנסים היום לפתח מענה מקיף לצורך במצברים זעירים: מיקרו-מצברים שמפיקים זרם גבוה וגם פועלים לאורך זמן. “המצברים המקובלים בנויים ממספר שכבות: קטודה, אנודה, אלקטרוליט ואוסף זרם, שיוצרים ביניהם תגובה אלקטרוכימית המפיקה חשמל", מסבירה ד"ר' גולודניצקי. "כשמקטינים את כמות החומר כדי לבנות סוללה זעירה, פוחתת גם כמות האנרגיה, והסוללה אינה יעילה. בנוסף, האלקטרוליט הוא נוזל רעיל שעלול לדלוף, ולכן סוללות מסוג זה אינן מתאימות לשימושים רפואיים, בתוך גוף האדם. כמו כן, מצברים קטנים עם שכבות דקות של אלקטרוליט מוצק, שפותחו לפני כ-15 שנה, זקוקים לטעינות תכופות מדי. פרופ' מנחם נתן מהפקולטה להנדסה הציע פתרון מבריק: שבב סיליקון מחורר, המכיל מספר גדול של מצברים בממדי ננו. קבוצת המחקר שלנו מפתחת מצברים זעירים המתבססים על הרעיון של פרופ' נתן".
לספק את המתח הנכון
המצברים הזעירים בנויים לתוך שבב סיליקון תלת-ממדי, ששטחו 1 סמ"ר ועוביו 500 מיקרון, ובו 20,000 עד 30,000 חורים דקים, בקוטר מיקרון, ובמרחק 10 מיקרון זה מזה. בעזרת שיטות חכמות של ‘כימיה רטובה' - תהליכי ציפוי שונים בתוך תמיסות - מצליחים החוקרים למקם בכל אחד מהחורים שכבות דקות המרכיבות ננו-מצבר עצמאי. בסך הכל מציע השבב פי 10 עד 40 יותר חומר פעיל לייצור חשמל, והספק גבוה פי 10 ליחידת שטח, בהשוואה למיקרו-מצברים אחרים. "אנו מפתחים מגוון מצברים העשויים מננו-חומרים שונים, כדי לספק מתח נכון לצרכים ולשימושים שונים", אומרת ד"ר' גולודניצקי. “לדוגמה, תאים סולאריים זקוקים למתח נמוך של 5 וולט, ומצברים המשמשים למטרות רפואיות פועלים בדרך כלל על מתח של 3 וולט ומעלה".
לבריאות ולביטחון
היישומים הפוטנציאליים של המצברים הזעירים רבים מאוד, ובהם: שתלים שמשחררים תרופות בגוף באופן מבוקר; קפסולות לבליעה הנושאות מיקרו-מצלמות להדמיה פנימית של מערכת העיכול (אנדוסקופיה); שתלים באוזן המסייעים לשמיעה; קוצבי לב; חיישנים למדידת לחץ דם או רמת האינסולין בדם; אגירת אנרגיה המופקת מהשמש על-ידי תאים סולאריים קטנים; חיישנים לניתור סביבתי ומדידת לחץ אטמוספרי; וחיישנים הפזורים בשטח למטרות ביטחוניות.
תאי דלק ירוקים
במחקרים אחרים נעזרו החוקרים בשיטות של ננוטכנולוגיה כדי לקדם יישומים מתחום האנרגיה, ובעיקר תאי דלק ‘ירוקים' ונקיים. "תא דלק הוא מתקן אלקטרוכימי שממיר באופן רציף אנרגיה כימית של דלק (כמו מימן) וחומר מחמצן (כמו חמצן או אוויר) לאנרגיה חשמלית", מסביר פרופ' פלד. "תאי הדלק הירוקים ידידותיים לסביבה, מכיוון שהם פולטים רק מים וחום לאטמוספרה, ובעשור האחרון הם מעוררים עניין רב ברחבי העולם כאמצעי לייצור ולאגירת אנרגיה בכלל ואנרגיה נקייה בפרט. הם יכולים לשמש לאגירת חשמל המיוצר מאנרגיית הרוח או השמש, ולאספקת חשמל לרשת או לבתים בודדים (בשילוב עם מיזוג אוויר), וכמובן גם למכשירים ניידים. אולם היישום המבטיח ביותר היום הוא הנעת כלי רכב חשמליים".
מרכיב חשוב בתאי הדלק הם הזרזים - חלקיקים ננומטריים שמאפשרים את תהליכי החמצון-חיזור המתרחשים בתא הדלק. הזרזים הקיימים היום עשויים בדרך כלל מננו–חלקיקים של פלטינה - מתכת יקרה במיוחד, שעלותה מגבילה מאוד את השימוש בתאי דלק. למעשה, מחיר הזרזים כיום הוא כמחצית ממחירו של תא הדלק כולו. כדי לייעל ולהוזיל את היישומים, פיתח הצוות של פרופ' פלד זרזים מסוג חדש: גרעין ננומטרי העשוי ממתכת אחרת, יקרה פחות, עטוף בקליפה דקה או בתת–קליפה של פלטינה או סגסוגת פלטינה. זרזים אלה מיוצרים בטכניקה נוחה של שיקוע אל-חשמלי, בטמפרטורת החדר. הם מפחיתים משמעותית את עלות תא הדלק, ובה בעת אינם פוגעים בביצועיו, ולעתים אף משפרים אותם.
מתוך החוברת "המהפכה הזעירה" בעריכת דוברת האוניברסיטה >>

מחקר
מחקר שנערך באוניברסיטת תל-אביב העלה כי תזונה מועשרת בשמן דגים משפרת את מצבם של פצעי לחץ ב-25-20 אחוזים

שמן דגים הוא חומר עשיר בחומצות שומן מסוג אומגה 3 ובנוגדי חמצון, הידוע בסגולותיו הרפואיות. הוא יכול לסייע להורדת לחץ הדם, להקלת דלקות בעור ובמפרקים, ולהתפתחות תקינה של עוברים. פרופ' פייר זינגר מהפקולטה לרפואה באוניברסיטת תל-אביב ומהמחלקה לטיפול נמרץ כללי והמכון לחקר התזונה בביה"ח בילינסון, גילה כי לשמן דגים יש השפעה מיטיבה גם על פצעי לחץ. המחקר ותוצאותיו פורסמו בשני כתבי עת מדעיים: ,British Journal of Nutrition ו-American Journal of Critical Care.
פצעי לחץ הן כידוע בעיה מוכרת בקרב חולים במצב קשה. הם נגרמים כשהחולה נמצא בתנוחת שכיבה או ישיבה, ללא תנועה, לאורך זמן, והמשטח שמתחתיו יוצר לחץ ממושך על העור והרקמות. "פצעי הלחץ מכאיבים מאוד ומזדהמים בקלות, ולכן חשוב מאוד לרפא אותם", אומר פרופ' פייר זינגר. במחקר שלנו הוספנו שמן דגים כתוסף תזונה לחולים קשים, ובדקנו את השפעתו על פצעי הלחץ."
במסגרת המחקר, שנערך בשיתוף עם הדוקטורנטית מרים תהילה מהמרכז הרפואי ע"ש רבין, קיבלו החולים שמונה גרם של שמן דגים מדי יום במשך שלושה שבועות. והתוצאות היו חיוביות ביותר: שיפור של 25-20 אחוז על פי מדד הריפוי של פצעי לחץ, שהתבטא בירידה משמעותית בכאב ובאי-נוחות שנגרמו לחולים. בנוסף נצפו עלייה ביעילותה של מערכת החיסון והפחתת דלקות בכל הגוף.
חיזוק המערכת החיסונית
המחקר של פרופ' זינגר ועמיתיו התבסס על מחקר קודם, שהראה כי תוספי תזונה המכילים שמן דגים מעלים את רמות החמצן ברקמות של חולים קשים. הפעם ביקשו החוקרים לבחון אם התוספים יכולים גם לסייע בריפוי פצעי לחץ, הנגרמים בין היתר בשל חוסר חמצן, ירידה בזרימת הדם ורטיבות העור.
כדי לבחון את השערתם פיתחו החוקרים מחקר אקראי שכלל 40 חולים קשים. מחציתם המשיכו לקבל את התזונה הרגילה של בית החולים, והאחרים קיבלו בנוסף גם שמונה גרם של שמן דגים מדי יום. כעבור שלושה שבועות נצפה שיפור של 25-20 אחוז בהחלמת פצעי הלחץ אצל החולים שקיבלו שמן דגים, בהשוואה לקבוצת הבקרה.
בנוסף לשיפור בפצעי הלחץ, נהנו החולים שקיבלו שמן דגים מהתחזקות מערכת החיסון והפחתה בנפיחויות. "מצאנו שינוי בביטוי של קבוצת מולקולות הקשורה להכוונת תאי דם לבנים לעבר פצעים, דבר העשוי להסביר את השיפור בתהליך הריפוי", מסביר מפרופ' זינגר. בנוסף, כשבדקו את דמם של החולים, הבחינו החוקרים בירידה משמעותית בכמות של חלבון מגיבC , הקשור למגוון מצבים ומחלות: דלקות, זיהומים ויראליים ובקטריאליים, מחלות ראומטיות, פגיעה ברקמות ונקרוזה.
אמצעי טבעי לניהול כאב?
כעת מבקשים פרופ' זינגר ועמיתיו לבחון את השימוש בשמן דגים כשיטה טבעית לניהול כאב. במסגרת המחקר המתוכנן הם ימדדו את השפעתה של צריכת שמן דגים על עוצמת הכאב בקרב חולים לאחר ניתוח להחלפת הברך או מפרק הירך.

מחקר
חוקרים מאוניברסיטת תל-אביב מצאו: מעקב של 40 שנה חושף תועלת משמעותית מהפחתה בכמות הסיגריות

קיימים אינספור מחקרים המצביעים על התועלות העצומות שבהפסקת העישון: ירידה בסיכון למחלות שונות, הארכת תוחלת החיים ושיפור איכות החיים. אך אנשי מקצועות הבריאות מודים כי הדרך להפסקת העישון היא לעתים ארוכה וקשה, ורק אחוז קטן מהמעשנים מצליחים להגיע אל סופה.
"רופאים פוגשים מדי יום במטופלים שאינם יכולים או אינם רוצים להפסיק לעשן", אומרת ויקי מאיירס, חוקרת מבית הספר לבריאות הציבור בפקולטה לרפואה של אוניברסיטת תל-אביב. "כדי להתמודד עם המציאות בשטח בחרו מאיירס ועמיתיה, ד"ר יריב גרבר ופרופ' אורי גולדבורט, לבחון את רמות השרידות ותוחלת החיים של מעשנים שהפחיתו את מספר הסיגריות, אך לא חדלו לעשן. הנתונים שעמדו לרשות החוקרים כיסו תקופה ארוכה במיוחד של 40 שנה.
השיפור הגדול ביותר נמצא כצפוי אצל מעשנים שחדלו לחלוטין לעשן – ירידה של 22% בסיכון לתמותה מוקדמת בהשוואה למעשנים שלא שינו מהרגלם. עם זאת, גם מעשנים שרק הפחיתו את כמות הסיגריות, נהנו מירידה משמעותית של 15% בסיכון. ממצאים אלה מראים כי הפחתה בעישון מהווה בהחלט אסטרטגיה ראויה לצמצום סיכונים. מאיירס מציינת שהתועלת הגדולה ביותר מן ההפחתה נרשמה בקרב מעשנים כבדים.
המחקר מאוניברסיטת תל-אביב פורסם בכתב העת American Journal of Epidemiology.
מעשנים פחות ומאריכים את החיים
כדי לבחון את השפעת ההפחתה בעישון לאורך זמן הסתמכו החוקרים על נתונים מן המחקר הישראלי על מחלת לב איסכמית, שהחל בשנת 1963 והקיף 4,633 גברים – כולם עובדים ומעשנים באותה עת. המשתתפים, שגילם הממוצע היה אז 51 , רואיינו בנוגע להרגלי העישון שלהם בתחילת המחקר, ושוב כעבור שנתיים, ב-1965. אחר כך נערך מעקב אחר אחוזי התמותה בקרבם לאורך 40 שנה.
בראיון הראשון חולקו המשתתפים לארבע קטגוריות על פי מספר הסיגריות שעישנו ביום: 0, 10-1, 20-11, ו-21 ומעלה. בראיון השני ציינו החוקרים אם במהלך השנתיים שחלפו המרואיין הפחית, הגביר או שמר על רמת העישון, או הפסיק לעשן. הפחתה או הגברה הוגדרו כתזוזה בקטגוריה אחת או יותר.
באופן בלתי מפתיע התברר כי אלה שהפסיקו לעשן נהנו מהשיפור הגדול ביותר – ירידה של 22% בתמותה הכוללת. אצל מעשנים שהפחיתו את כמות העישון וירדו בקטגוריה אחת או יותר נמצאה ירידה של 15% בסיכון לתמותה בכלל, וירידה של 23% בסיכון למוות ממחלת לב. בנוסף מדדו החוקרים את שרידותם של משתתפי המחקר עד גיל 80. הם מצאו כי מי שחדל לעשן נהנה מסיכוי מוגדל ב-33% להגיע לגיל 80, ואילו אצל המפחיתים גדל הסיכוי ב-22%.
המחקר של הצוות מאוניברסיטת תל-אביב הוא מהבודדים שמתייחסים גם להפחתה בעישון, ולא רק להפסקה מוחלטת, ולדברי מאיירס ממצאיו מעידים באופן ברור כי עדיף להפחית מאשר לא לעשות דבר. "רבים מהמחקרים בוחנים שינויים לטווח קצר", היא אומרת, "אך כדי להוכיח את השפעתה החיובית של ההפחתה נדרש מעקב לאורך שנים רבות, מכיוון שהנזק שגורם העישון ותהליך ההחלמה ממנו אורכים זמן רב".
אף פעם לא מאוחר מדי
אחת המסקנות החשובות ביותר של המחקר היא שאף פעם לא מאוחר מדי לשנות את הרגלי העישון. משתתפי המחקר המקורי, שהיו בממוצע כבני 50 בתחילתו, יכלו עדיין להפסיק או לצמצם את העישון, וליהנות מתוצאות המאמץ לטווח הארוך. "אופציית ההפחתה שנויה במחלוקת, כי חלק מאנשי מקצועות הבריאות סבורים שהיא מחלישה את המסר שחייבים להפסיק לעשן. גם אנו ממליצים יותר מכל על הפסקת העישון, ועם זאת הוכחנו כי כאשר לא ניתן להפסיק, הפחתת העישון אף היא אסטרטגיה שמצמצמת סיכונים. לפיכך אנו ממליצים למעשנים לנקוט בכל צעד שהוא אפשרי מבחינתם, כדי לשפר את בריאותם לטווח הארוך," מסכמת מאיירס.

מחקר
בעקבות האוצר הימי: ד"ר נועה שנקר, ביולוגית ימית מאוניברסיטת תל-אביב, עומלת על מרשם מיליון המינים בסביבה הימית, עם קבוצת מדענים מ-32 מדינות

מוצאים את נמו
העשור האחרון היה העשור הפרודוקטיבי ביותר בתחום גילוי מינים חדשים למדע, ועם זאת עדיין ידועים רק כשליש מהמינים בסביבה הימית. על בסיס מאגר רישום המינים הימיים שייסד צוות מומחים בינלאומי, הוכנה לראשונה רשימה של כל המינים הידועים כיום בסביבה הימית ובוצעה הערכה לגבי מספר המינים שעוד לא נתגלו. ממצאי המחקר יוכלו לסייע במאמצים לשימור מינים ולהערכת סכנת ההכחדה המאיימת עליהם. הממצאים המלאים של הפרויקט המחקרי המכונה "מרשם המינים הימיים העולמי", פורסמו בכתב העת "Current Biology".
ד"ר נועה שנקר מהמחלקה לזואולוגיה באוניברסיטת תל-אביב, לקחה חלק בקבוצת המרשם שהתמקדה במינים ממחלקת האצטלנים – בעלי חיים חסרי חוליות, וריכזה את המידע הנוגע לים סוף ומזרח הים התיכון. במחקריה הטקסונומיים תיארה ד"ר שנקר שלושה מינים שלא היו מוכרים למדע. כנהוג, זכו המינים לשמות פרי מחשבתה, אחת הפריבילגיות שמגיעות עם התפקיד. לאחד מהם קראה רופלאה עידונטע, שילוב של שמות ילדיה - עידו ונטע, ואילו למין אחר קראה בולטיניה יוסי לויה, על שמו של פרופ' יוסי לויה, ראש מעבדה לביולוגיה ימית באוניברסיטת תל-אביב.
מחקר על רטוב
למרות הדימוי הרווח של טקסונומים כחוקרים המעבירים את ימיהם סגורים במעבדה ומוקפים בצנצנות מלאות בפורמלין, מדובר, לדברי ד"ר שנקר, בתחום מחקר אטרקטיבי מאוד, הכולל הרבה עבודת שטח. בתחום הביולוגיה הימית מדובר כמובן בצלילות, המאפשרות להגיע לעומק רב ולאתר מינים חדשים.
20,000 מינים חדשים מתחת למים
מתוצאות מרשם המינים עולה כי ידועים כיום כ-226,000 מינים בסביבה הימית. בעשור האחרון התגלו כ-20,000 מינים חדשים, יותר מינים מאשר בכל עשור אחר. כמו כן מספר החוקרים העוסקים בתיאור מינים חדשים עלה בצורה משמעותית ב-60 שנים האחרונות. עוד עולה מן המחקר, כי בממוצע כ-37% מהמינים בלמעלה ממאה איסופי שדה מרחבי העולם, הם מינים חדשים למדע.
בין 58,000 ל- 72,000 מינים חדשים התגלו אך טרם תוארו, ובין 482,000 ל-741,000 מינים חדשים עוד אמורים להתגלות. שיטות מולקלוריות יכולות להוסיף עוד אלפי מינים קריפטים (מינים זהים מורפולוגית אך שונים מבחינה מולקולרית).
המסקנה העיקרית שעלתה מן המחקר היא כי בין שליש לשני שליש מהמינים בסביבה הימית עדיין לא תוארו, וההערכה היא שקיימים בין 0.7 ל-1 מיליון מינים בסביבה הימית. אם מגמת העלייה של גילוי המינים תמשיך, ההערכה של צוות המומחים היא שעד לסוף המאה מרבית המינים בסביבה הימית יתגלו.

מחקר
חוקרים מאוניברסיטת תל-אביב הובילו את הפרויקט הבינלאומי העשוי לשנות את מפת המחקר והרפואה בתחום המוח

בשיתוף מוחות
חוקרים מאוניברסיטת תל-אביב הובילו פרויקט מחקר אירופי רחב היקף שכלל 12 קבוצות חוקרים, שבנו לראשונה אטלס מלא של מיקרו-מבנים בחומר הלבן של המוח האנושי. הפרויקט, שעשוי לשנות בשנים הבאות את מפת המחקר והרפואה בתחום המוח, הסתמך על טכנולוגיית ה-MRI, וזכה לתמיכה של 2.5 מיליון יורו מהאיחוד האירופי, בקטגוריית 'טכנולוגיות העתיד'. השותפים במחקר - שכונה CONNECT – פועלים במרכזי מחקר מובילים בישראל, אנגליה, גרמניה, צרפת, דנמרק, שוויצריה ואיטליה. ביום שישי, 19.10.12, בתום שלוש שנות מחקר, הם עתידים להתכנס בפריס ולהכריז על סיומו המוצלח של הפרויקט.
מוח האדם בתלת מימד
"היום נעזרים צוותים רפואיים וקבוצות מחקר באטלס ישן של המוח, המתבסס על מוחו של אדם אחד, אשר תרם את גופו למדע." מסביר פרופ' יניב אסף מהמחלקה לנוירוביולוגיה באוניברסיטת תל-אביב ומבית הספר סגול למדעי המוח, שיזם את המחקר הבינלאומי ושימש כמתאם קבוצות המחקר, "האטלס החדש, לעומת זאת, מבוסס על דגימות MRI של נבדקים רבים, ואף מוגש בתלת מימד. לפיכך, בזכות שיטת המחקר והיקפו, הוא מפורט ומדויק הרבה יותר. למעשה, האטלס החדש מאפשר לנו לבחון את המוח בדרך שהייתה אפשרית קודם רק במיקרוסקופ".
החידוש הראשון באטלס טמון בעצם מיפויו של החומר הלבן - המורכב מסיבי עצב המעבירים מידע - במוחם של אנשים חיים, ולא בנתיחה שלאחר המוות. פריצת הדרך התאפשרה בזכות טכנולוגייתMRI , שמסוגלת ליצור תמונה של המוח החי בהליך בלתי חודרני. שנית, האטלס החדש אינו מסתפק במידע ממוח אחד, אלא מסתמך על הדמיית מוחותיהם של 120 נבדקים בריאים, בני 35-25 שנים. הנתונים, שקובצו ועובדו בטכניקות עיבוד תמונה מתקדמות, נותנים תמונה רחבה ומדויקת של מבנה המוח התקין.
האטלס החדש מציג מיקרו-מבנים זעירים בכל רחבי המוח באופן מסודר ומקודד, המתאים גם למשתמש שאינו מומחה בחקר המוח, כגון רופא או חוקר מתחום אחר. התמונות מייצגות פרמטרים מגוונים, שנאספו ונמדדו באמצעות ה-MRI, כמו למשל עובי הסיבים וצפיפותם באזורים השונים. הן נועדו לשמש סטנדרט של מוח בריא, שאליו ניתן להשוות הדמיות ממוחות של מטופלים ונבדקים עתידיים.
מהחומר האפור לחומר הלבן
בנוסף לתרומתו הרפואית, צפוי הפרויקט להאיץ ולקדם באופן משמעותי את חקר החומר הלבן במוח, פעילותו ותפקודיו. "עד היום התמקדו מדעני המוח בעיקר במה שמכונה 'החומר האפור'," אומר פרופ' אסף. "הם נמנעו מלחקור את 'החומר הלבן', המהווה כמחצית מנפח המוח, בעיקר מפני שחסרו להם שיטות מחקר יעילות. שיטת ה-MRI שפיתחנו תאפשר לחוקרים לראשונה להתבונן במתרחש בסיבי העצב במוח החי, ותפתח בפניהם עולם של אפשרויות חדשות".
בין היתר מתכוונים פרופ' אסף ועמיתיו להיעזר בטכנולוגיה כדי לבחון את הדינמיות וההשתנות לאורך זמן של המיקרו-מבנים שבחומר הלבן. כך לדוגמה, הם יחפשו את טביעת האצבע שמותיר תהליך קוגניטיבי, כמו למידת נושא חדש, בסיבים שבמוח. כיוון מחקר נוסף הוא אפיון והבנת השינויים שגורמות מחלות שונות במוח האנושי, כמו אלצהיימר או סכיזופרניה, במטרה לפתח שיטות אבחון יעילות ואמינות.

מחקר
מחקר חדש שופך אור על הדמיון בין התקשורת החברתית של חיידקים לזו של תאים סרטניים ומציע כיווני מחקר חדשים למאבק בסרטן

הפייסבוק של החיידקים ושל תאי הסרטן
במעבדתו של פרופ' אשל בן-יעקב מבית הספר לפיזיקה ולאסטרונומיה בפקולטה למדעים מדויקים ע"ש ריימונד ובברלי סאקלר חוקרים את התנהגותם החברתית של חיידקים. אולם, לא רק החיידקים חולקים ביניהם תקשורת חברתית ענפה. "כמו החיידקים, גם תאי סרטן מסתמכים על תקשורת ועל שיתוף פעולה", טוען פרופ' בן-יעקב.
שיתוף פעולה בין חוקרי מעבדתו של פרופ' בן-יעקב ובין החוקרים האמריקאיים פרופ' דונלד קופי, חוקר סרטן מאוניברסיטת ג'ונס הופקינס, ופרופ' הרברט לוין מאוניברסיטת רייס, העלה תוצאות מעניינות אודות התנהגותם החברתית של תאי סרטן. המחקר מצביע על דמיון בין מנגנון התקשורת החברתית של חיידקים לבין מנגנון התקשורת שחולקים תאים סרטניים בגופם של חולים. המודל שמוצג במחקר מתאר שיתוף פעולה בין תאי סרטן המאותתים זה לזה על אזורים בהם ניתן להתיישב ולפתח גרורות סרטניות. תוצאות המחקר התפרסמו בכתב העת המדעי Trends in Microbiology.
ריגול ומודיעין
תאים בריאים בגוף מתנהגים בהתאם לאותות ולהוראות הכימיים והפיזיקליים שהגוף שולח. לעומתם, חיידקים ותאים סרטניים מצליחים להתרבות על ידי עקיפה של מערכת החיסון ושיגור מסרים לשיבוש פעילותה. בכדי להשיג יעדים אלו, משתמשים תאי הסרטן באינטראקציות מורכבות על מנת לחלוק משאבים ולחלק משימות באופן יעיל בינם לבין עצמם.
"לפני שתאים סרטניים מתפשטים בגוף ויוצרים גרורות, הם שולחים לכל חלקי הגוף נציגים המתפקדים כ'תאי ריגול' ומנווטים את תאי הסרטן במקור הגידול אל האזורים בהם ניתן להתיישב ולפתח גרורות", מתאר פרופ' בן-יעקב. רק לאחר השלמת תהליך זה, עוזבות הגרורות את מקור הגידול הסרטני ומתפשטות בגוף. בנוסף, יש ביכולתם של תאים סרטניים לשנות את סביבתם ולהכריח תאים בריאים לספק להם תמיכה והגנה באמצעות שינויים גנטיים, בדומה לחיידקים.
לבלבל את האויב
לדברי פרופ' בן-יעקב, חקר התנהגותם החברתית של תאי סרטן יכול להוביל לכיווני מחקר חדשים ולדרכים חדשות להתמודד עם המחלה, לדוגמא, פיתוח סוג חדש של תרופות נגד סרטן אשר משבשות את התקשורת בין התאים ושולחות מסרים שגויים על מנת להאט או לעצור את התפשטות המחלה.
בין היתר, חקר פרופ' בן-יעקב בעבר את תופעת הקניבליזם בקרב מושבות חיידקים ופיצח את הקוד התקשורתי שהוביל את החיידקים להרוג זה את זה. בן-יעקב מציע לבחון את תופעת ה"קניבליזם" גם בקרב תאי הסרטן. תאים לעיתים טורפים אחד את השני כאשר משאביהם נגמרים. בעזרת האותות הנכונים יתכן כי חוקרים יוכלו להורות לתאי סרטן לתקוף ולחסל האחד את השני.
הצעה נוספת שהעלה צוות המחקר קשורה ביכולתם של תאי סרטן להיכנס ל"תרדמת" כאשר החולה עובר כימותרפיה ולהתעורר שוב לאחר סיום הטיפול. על פי פרופ' לוין ייתכן כי היכולת לפענח את אמצעי התקשורת בין תאים סרטניים תאפשר לרופאים "לעורר" את אותם תאים רדומים ולהורגם על ידי שליחת מסרים מתאימים. מסרים אלו יכולים להישלח באמצעות חיידקים.
חוקרים אחרים כבר הדגימו בעבר כי חיידקים מוזרקים הצליחו "להערים" על תאי סרטן ו"ללמד" את מערכת החיסון לזהות את התאים הסרטניים ולחסלם. "יתכן ואנו נכנסים לעידן חדש של ‘מלחמה סייבר ביולוגית' בסרטן שבה מדענים יכולים לרתום את האינטליגנציה של החיידקים על מנת להביס תאים סרטניים", מסכם פרופ' בן-יעקב.